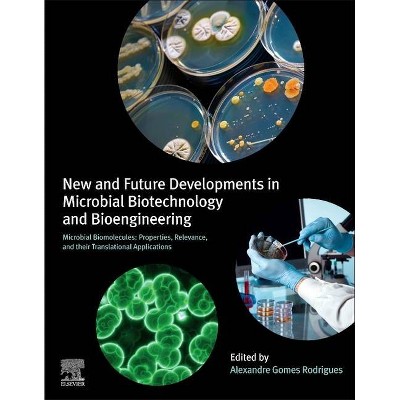
New and Future Developments in Microbial Biotechnology and Bioengineering - by  Alexandre Gomes Rodrigues (Paperback)

Biotechnology of Microbial Enzymes - by Hazel Nygel (Hardcover)

Similar Products
Products of same category from the store
AllProduct info
<p/><br></br><p><b> About the Book </b></p></br></br>Enzymes are biological catalysts, which help in accelerating chemical reactions in the cells and thereby helps in sustaining life. Microorganisms are a primary source for deriving enzymes. Bacteria, fungi and yeast are some of the commonly used microorganisms used to extract enzymes for diverse industries such as pharmaceuticals, food, textiles, animal feed, etc. Microbes can be genetically modified which makes them a better source of enzymes. Such selected concepts that redefine this field of study have been presented in this book. The various advancements in microbial enzymes are glanced at and their applications as well as ramifications are looked at in detail. For all readers who are interested in this field, the case studies included in this book will serve as an excellent guide to develop a comprehensive understanding.
Price History
Price Archive shows prices from various stores, lets you see history and find the cheapest. There is no actual sale on the website. For all support, inquiry and suggestion messages communication@pricearchive.us